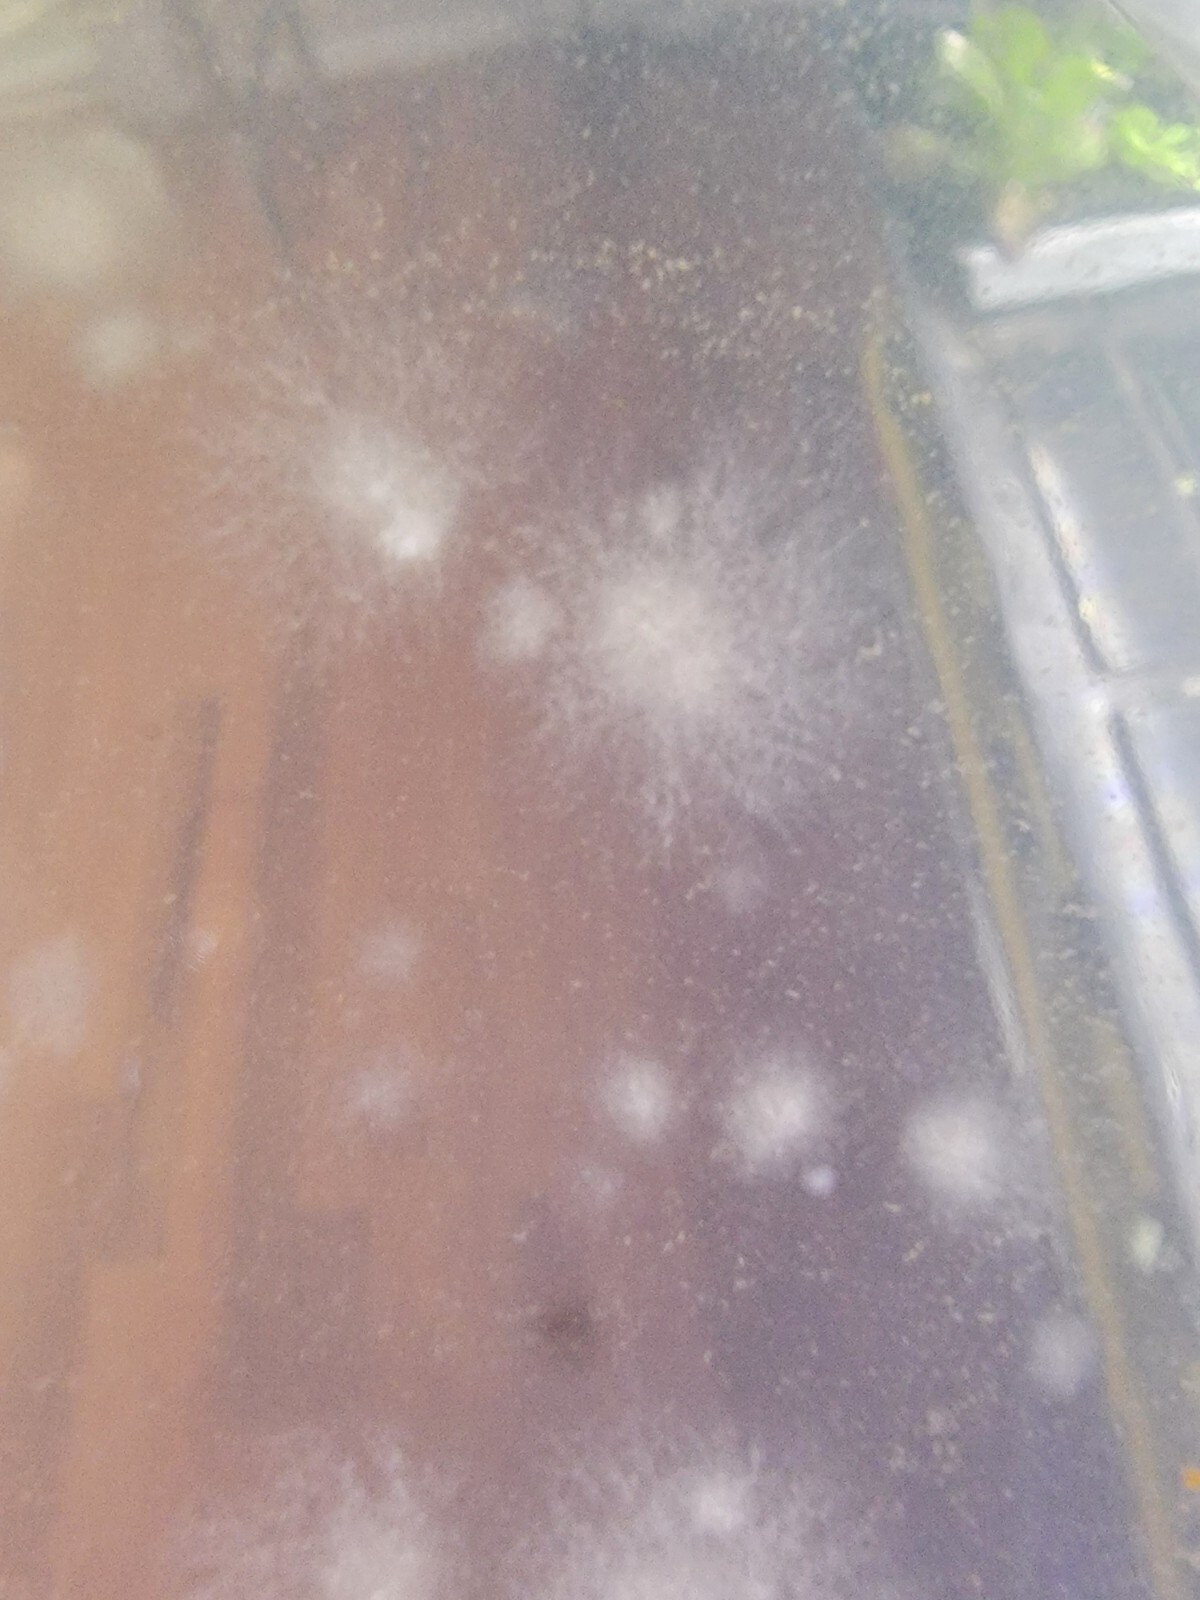

Каталог
- Одежда, обувь и аксессуары
- Компьютеры
- Электроника
- Фото и видеокамеры
- Сотовые телефоны и аксессуары
- Товары для детей
- DVD-диски и фильмы
- Товары для красоты и здоровья
- Дом и Сад
- Товары для ванны
- Постельные принадлежности
- Еда и вино
- Ванна
- Мебель
- Праздники, Открытки И Вечеринки
- Домашний Декор
- Благоустройство Дома
- Уборка
- Дети и подростки
- Кухня, Столовая И Бар
- Лампы, Светильники И Потолочные Вентиляторы
- Ковры
- Инструменты
- Свадебные Принадлежности
- Мытье Окон
- Двор, Сад & Природа
- Оптом
- Другие
- Свежие Срезанные Цветы И Материалы
- Праздник & Сезонные Декор
- Крупная Бытовая Техника
- Другое Дом И Сад
- Праздничный и сезонный декор
- Кухонные Принадлежности
- Праздничный и сезонный декор
- Школьные принадлежности
- Кухонные Принадлежности
- Школьные принадлежности
- Праздничный и сезонный декор
- Кухонные Принадлежности
- Школьные принадлежности
- Праздничный и сезонный декор
- Кухонные Принадлежности
- Часы и бижутерия
- Музыка
- Музыкальные инструменты и принадлежности
- Товары для домашних животных
- Керамика и стекло
- Спортивные товары
- Игрушки
- Видеоигры
- Оборудование для предприятий
- Хобби